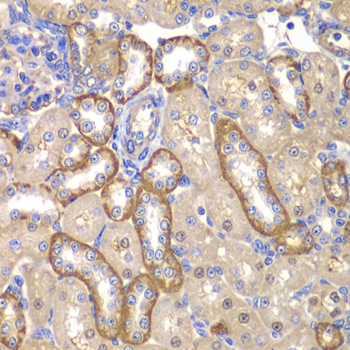
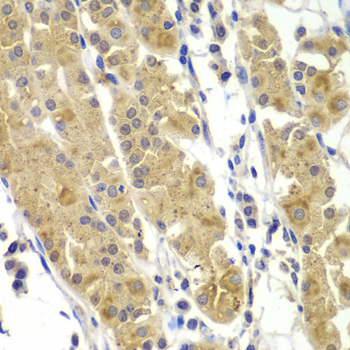

For quotations, please use our online quotation form, and you may also contact us by
service@kendallscientific.com
+1-888.733.6849 (Toll-free)
+1-617.299.7367 (Int’l))
+1-888.733.6849
Our customer service representatives are available 24 hours, Monday through Friday to assist you.| Reactivity | Human Mouse Rat |
| Tested applications | WB IHC |
| Recommended Dilution | WB 1:500 - 1:2000 IHC 1:50 - 1:100 |
| Calculated MW | 65kDa |
| Observed MW | Refer to Figures |
| Immunogen | Recombinant protein of human MMP14 |
| Storage Buffer | Store at -20℃. Avoid freeze / thaw cycles. Buffer: PBS with 0.02% sodium azide, 50% glycerol, pH7.3. |
| Synonym | MMP-14; MMP-X1; MT-MMP; MT1MMP; MTMMP1; WNCHRS; MT1-MMP; MT-MMP 1; |

Western blot analysis of extracts of various cell lines, using MMP14 antibody.
Immunohistochemistry of paraffin-embedded rat kidney using MMP14 antibody at dilution of 1:100 (40x lens).

Immunohistochemistry of paraffin-embedded human liver cancer using MMP14 antibody at dilution of 1:100 (40x lens).

Immunohistochemistry of paraffin-embedded human kidney using MMP14 antibody at dilution of 1:100 (40x lens).
Immunohistochemistry of paraffin-embedded human gastric using MMP14 antibody at dilution of 1:100 (40x lens).

Immunohistochemistry of paraffin-embedded human prostate using MMP14 antibody at dilution of 1:100 (40x lens).
Proteins of the matrix metalloproteinase (MMP) family are involved in the breakdown of extracellular matrix in normal physiological processes, such as embryonic development, reproduction, and tissue remodeling, as well as in disease processes, such as arthritis and metastasis. Most MMP's are secreted as inactive proproteins which are activated when cleaved by extracellular proteinases. However, the protein encoded by this gene is a member of the membrane-type MMP (MT-MMP) subfamily; each member of this subfamily contains a potential transmembrane domain suggesting that these proteins are expressed at the cell surface rather than secreted. This protein activates MMP2 protein, and this activity may be involved in tumor invasion.
N/A